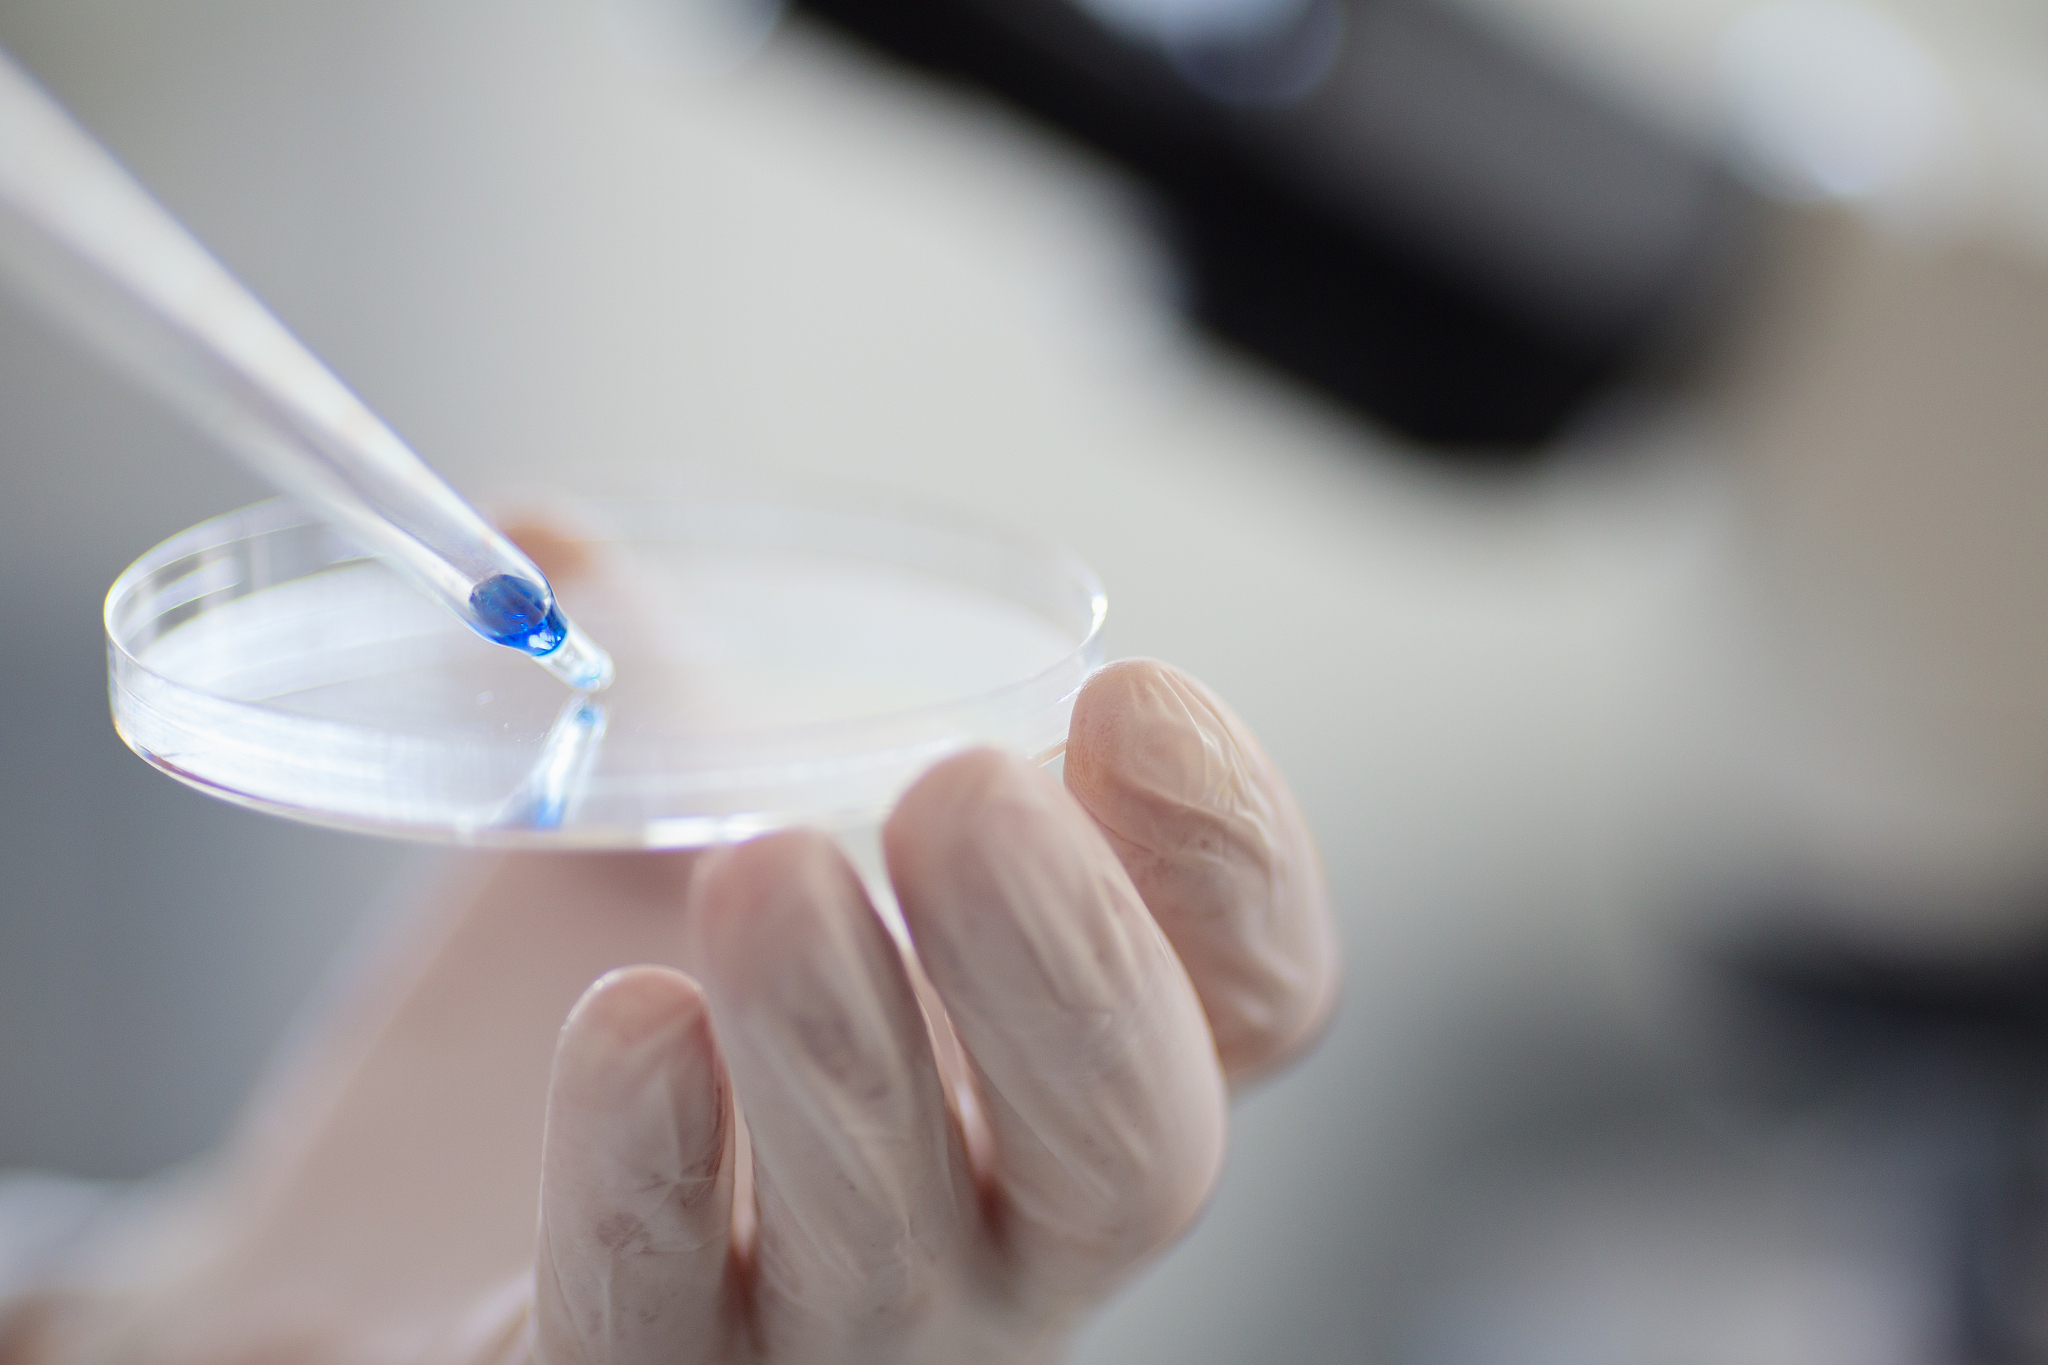
湖南科技职业学院3+2五年制大专招生简章 - 培养高素质技能型人才

湖南科技职业学院3+2五年制大专招生简章 - 培养高素质技能型人才
湖南科技职业学院是一所以培养高素质技能型人才为目标的学院,近日宣布开设'3+2'五年制大专招生计划。该计划旨在为学生提供更多的学习机会和职业发展空间,帮助他们在未来的职场中更好地立足。
湖南科技职业学院是一所以技能教育为主的学院,不仅注重学生的理论学习,更注重学生的实践能力。在学院的帮助下,学生们能够在校内外参加各种实践活动,锻炼自己的实践能力和创新能力。
在学院的教育体系中,实践教学被赋予了重要的地位。学院不仅拥有一支高素质的教师团队,还与各大企业和机构建立了合作关系,为学生提供实践机会和实习岗位。学生们在这些机会中,不仅能够学到理论知识,更能够将所学知识应用到实践中,提高自己的综合素质。
除了实践教学,学院还注重学生的职业发展。学院为学生提供职业规划和就业指导服务,帮助学生更好地了解职场和市场需求,为他们的职业发展提供有力的支持。同时,学院还与各大企业和机构建立了校企合作关系,为学生提供更多的就业机会和实践机会。
在湖南科技职业学院的教育体系中,学生们不仅能够获得优质的教育资源,更能够锻炼自己的实践能力和职业素养。相信在这样的教育环境中,学生们一定能够取得更好的成绩和职业发展。
原文地址: https://www.cveoy.top/t/topic/gapn 著作权归作者所有。请勿转载和采集!